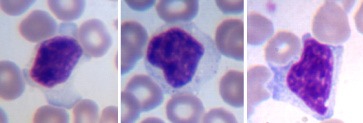

Содержание
- Анализ крови и его виды
- Результаты анализа крови при ЖДА
- Биохимический анализ крови
- Как правильно подготовиться к исследованию?
- Что может влиять на результат?
- Оценка качества лечения железодефицитной анемии по результатам анализов
- Где проводят диагностику крови и какова стоимость каждого анализа?
- Важные замечания
- Вывод
- Вопрос-ответ
- Советы
Эта болезнь часто встречается при патологиях внутренних органов. Нередко она возникает когда женщина беременна или у ребёнка начинается период активного роста, нарушены процессы всасывания в кишечнике или есть серьёзное наследственное заболевание. Для диагностирования анемии врачи берут кровь из вены больного и проводят её лабораторное исследование.
Врачи используют для диагностирования заболевания несколько способов:
- Общее исследование (определение объёма жидкости, уровень гемоглобина, вычисление формулы лейкоцитов)
- Биохимия крови (уровень железа, трансферрина, Витамина В2, билирубина и других показателей в организме).
- Анализ на скрытую кровь в каловых массах (помогает понять есть ли кровотечение в желудочно-кишечном тракте).
Анализ крови и его виды
Методы исследования можно разделить на несколько разновидностей:
- общий
- биохимический анализ
- исследование на скрытую кровь
Врачи подчеркивают важность анализа крови при диагностике железодефицитной анемии, так как он позволяет оценить уровень гемоглобина, количество эритроцитов и содержание железа в организме. Специалисты отмечают, что ключевыми показателями являются уровень ферритина и трансферрина, которые помогают определить запасы железа. При низком уровне ферритина врачи могут заподозрить дефицит железа, даже если гемоглобин еще находится в пределах нормы. Кроме того, анализы могут выявить сопутствующие заболевания, которые могут усугублять анемию. Важно, чтобы пациенты не игнорировали симптомы, такие как усталость и слабость, и своевременно обращались к специалистам для проведения необходимых исследований. Правильная интерпретация результатов анализов позволяет врачам назначить адекватное лечение и предотвратить развитие серьезных осложнений.

Общий анализ
Самый универсальный и распространённый способ исследования. Он не подразумевает больших затрат и на то, чтобы исследовать кровь не нужно много времени. С его помощью можно понять состояние системы кроветворения.
Брать его можно двумя способами: из пальца (путём прокола пальца одноразовой иглой, если необходим один анализ) или из вены (рука затягивается жгутом, забор осуществляется одноразовым шприцем, такой анализ используется сразу для нескольких исследований, а объем исследуемой жидкости больше).
Биохимия крови
С помощью такого анализа можно понять сколько в крови химических веществ и какого состояние внутренних органов, какие в организме пациента есть недуги.
Анализ проводится на десятки показателей, среди них концентрация сывороточного железа, уровень ферритина, общая железосвязывающая способность сыворотки.
Анализы крови при железодефицитной анемии играют ключевую роль в диагностике и мониторинге состояния пациента. Многие люди отмечают, что результаты анализов помогают понять, насколько серьезна проблема и какие меры необходимо предпринять. Врач может назначить общий анализ крови, который покажет уровень гемоглобина и количество эритроцитов. Часто пациенты делятся, что важно не только получить результаты, но и правильно их интерпретировать. Например, низкий уровень ферритина может указывать на истощение запасов железа в организме. Люди также подчеркивают, что регулярные анализы помогают отслеживать эффективность лечения и корректировать его при необходимости. Важно помнить, что анализы — это первый шаг к восстановлению здоровья, и их результаты могут значительно повлиять на качество жизни.

Исследование кала на скрытую кровь
Причиной такого явления может стать наличие у пациента болезни Крона, язвенной болезни, опухоли в ЖКТ и ряд других заболеваний.
При кровотечении из нижних отделов кишечника кал окрашивается в ярко-алый цвет, а из верхних отделов кровь в каловых массах становится тёмной, почти чёрной.
Если такие явления однократные, то они не ведут к появлению ЖДА, а если они длительные или периодические, то несут большой вред организму пациента.
Общий анализ крови, выполненный «ручным» методом
Забор анализа осуществляется в утреннее время до приёма больным пищи. Дополнительно палец дезинфицируют, прокол делают одноразовой иглой.

- СОЭ
- концентрацию гемоглобина
- лейкоциты и эритроциты
- мазок
Для ручного исследования берут аппарат и капилляры Панченкова, раствор лимоннокислого натрия (5%), стекло, спирт и другие вспомогательные средства.
СОЭ исследуют методом выдувания жидкости на стекло из капилляра Панченкова на часовое стекло и замера этой скорости.
Для концентрации уровня гемоглобина используется колометрический способ исследования. Жидкость помещают в специальный раствор и сравнивают цвет со стандартом гемометром Сали.
Для получения уровня эритроцитов и лейкоцитов её дополняют раствором соли или уксусной кислоты и помещают в счётную камеру.
Расчёт цветового показателя
Понимая, сколько составляет уровень эритроцитов в крови и концентрацию гемоглобина можно понять насыщение эритроцита.
Для вычисления используется формула: ( уровень полученного гемоглобина* уровень полученных эритроцитов)/ (нормальный уровень гемоглобина* нормальный уровень эритроцитов).
Исследование мазка

Подсчёт ретикулоцитов берётся там: специалист считает попавшие в обзор узла зрения 1000 эритроцитов и считают сколько ретикулитов. Это количество делят на 10 и сравнивают с нормальным показателем.
Похожим образом считают и лейкоцитное значение крови у пациента.
Анализ крови, выполненный на автоматическом анализаторе крови
Уже сейчас на вооружении многих лабораторий стоят специальные автоматические приборы — гематологические анализаторы крови.
Такой аппарат заправляют реактивами, он работает от розетки. Внутрь прибора ставится пробка со взятой у пациента кровью. Аппарат обрабатывает полученный анализ и выдаёт бланк с результатами.
Сложности у такой машины возникают только с расчётом лейкоцитарной формулы, обычные модели могут производить расчёт только общего количества.
Автомат не считает только недоразвитые нейтрофилы.
Их считают врачи, изучая мазок крови.
Биохимическое исследование

Для изучения берётся крови из вены в области локтя. Если к ней нет доступа, то можно осуществить забор с другого места. Перед пункцией место прокола обрабатывается антисептиком.
За 8 часов до забора крови нельзя пить, есть. За 2 дня до исследования пациент обязан исключить алкогольные напитки и жирные блюда из своего меню.
Не рекомендуется нервничать, сильно нервничать и физически напрягаться.
Общий анализ крови
Этот метод считается самым универсальным и распространённым. Его проходят не только для выявления заболеваний, но и на профосмотрах, в школах, в армии.
Он показывает сколько в субстанции лейкоцитов, гемоглобина, уровень СОЭ, цветовой показатель и другие жизненно важные показатели.
Такой анализ покажет реакцию организма на процессы, которые происходят в организме пациента. Забор крови осуществляется в утреннее время. За 4 часа до него нужно отказаться от приёма пищи и воды. Для исследования используется кровь из пальца, реже делается пункция вены.
С помощью такого исследования можно найти значение до 24 показателей, а автоматические приборы способны выдать результаты практически сразу после анализа.
Посмотрите видео про общий анализ крови

Характеристика мазка периферической крови
Для выявления количественных величин и расчёта средних значений оценка показателей с помощью автоматизированного оборудования гораздо эффективней, в сравнении с ручными методиками.
Но автоматизированный метод неэффективен для диагностирования редких болезней крови, незрелых гранулоцитов и других показателей.
Какие показатели можно проверить с помощью мазка?
- Эритроциты. Их изменения могут сулить пациенту нарушения лимфоцитарного или плазмоцитарного характера. Аномалии этих компонентов в крови могут свидетельствовать о конкретных заболеваниях.
- Тромбоциты. Их количество правильно выявляется и при помощи автоматического исследования, но при слипании этих компонентов между собой этот показатель может стать ошибочным.
- Лейкоциты. С помощью мазка лаборант может найти морфологические аномалии, посмотреть кровь на редкие составляющие (моноциты, базофилы и т. д.). Кроме того, с помощью мазка можно найти токсическую зернистость.
Мазок исследуется одним специалистом.
Результаты анализа крови при ЖДА

Для мужчин нормальное значение у мужчин составляет показатели от 130 до 160 г/л, у женщин от 120 до 140 единиц, у пациентов подросткового возраста от 125 до 145 г/л.
Нормальные значения эритроцитов в крови должны быть равны:
- мужчины: от 3, 8-5, 6 млн/мкл.
- женщины от 3, 7– 5, 7 млн/мкл.
- пациенты подросткового возраста от 3, 7 до 5, 2 млн/мкл.
Нормой для цветового показателя у пациентов мужского пола варьируются от 0, 83 до 1, 05 ед., а у женщин от 5 до 17 единиц.
Гемоглобин при ЖДА
Уровень гемоглобина варьируется в зависимости от степени тяжести болезни, например, при лёгкой степени его содержание в крови равно от 110 до 90 Г/л, а при тяжёлой гемоглобин падает ниже 70 г/л, что создаёт угрозу жизни и здоровью.
Низкий уровень эритроцитов в субстанции только указывает на наличие анемии. А увеличение уровня ретикулоцитов, наоборот, говорит о том, что эритроциты в крови начинают быстро разрушаться и малокровие в организме прогрессирует.
Цветовой показатель указывает на то насколько насыщены гемоглобином эритроциты.
Если этот показатель ниже нормы, но нередко это может быть клиническим признаком анемии.
По этому критерию существует несколько разновидностей болезни:
- гипохромная (показатель падает ниже 0, 8 единицы)
- нормохромная (от 0, 8 до 1, 05)
- Геперхромная (коэффициент поднимается выше 1, 05)
Если коэффициент очень высокий, то это значит, что человеку не хватает витамина В12 или фолиевой кислоты. Но цветовой показатель может быть нормальным при постгеморрагической разновидности.
При недостатке железа, наоборот, цветовой показатель уменьшается.
МСНС
Эта единица измерений указывает на то сколько гемоглобина содержится в одной клетке. Если коэффициент опускается ниже уровня 29 г/дл., то это наверняка железодефицитная анемия.
Биохимический анализ крови
Сывороточное железо
Если долгое время организму не хватает железа, то этот компонент снижается до предела 14, 3– 17, 9 мкмоль/л.
Нормальный уровень значений варьируется от 17, 9 до 22, 5 единиц.
Уровень ферритина

Железосвязывающая способность сыворотки
Если трансферрина становится много, то это говорит о том. Что организм пациента испытывает дефицит железа.
По количеству компонента в несвязанном состоянии может говорить о степени недостатка компонента.
Эритропоэтин
Этот компонент выделяется с помощью почек, когда в организме начинается кислородное голодание. Но если у человека анемия, то этот компонент редко бывает повышенным.
Как правильно подготовиться к исследованию?
Подготовка к анализам стандартная:
- Пациент не должен есть перед исследованием, не рекомендуется принимать жидкость. За двое суток до забора крови рекомендуется прекратить приём алкогольных напитков и не рекомендуется курить.
- Кроме того, пациенту не следует перенапрягаться, нервничать, есть жирную пищу.
Что может влиять на результат?
Негативно может повлиять на результат воспаления в организме пациента, которые находятся на хронической стадии. Искажаются результаты при переливании крови или её компонентов, если были введены внутривенные препараты.
Негативно влияет на результаты приём пищи или жидкости до забора крови, употребление медикаментов.
Оценка качества лечения железодефицитной анемии по результатам анализов
Если соотносить результаты проведённого анализа с диагностикой анемии, то можно проследить следующие закономерности.
При возникновении анемии, как правило, уровень сывороточного железа в крови уменьшается до 40 единиц.
При дефиците железа в лёгкой стадии ОЖСС может быть в нормальном значении или чуть повышаться.
Трансферрин тоже увеличен, но не всегда это свидетельствует о том. Что у пациента есть анемия. Подобные проявления возможны и при ряде других заболеваний.
При ЖДА лейкоциты понижены примерно на 10% от общей нормы, а сывороточный билирубин не повышается. Уровень тромбоцитов находится в норме, но нередко у детей он становится немного повышенным.
Продолжительность жизненного цикла эритроцитов чаще обычная, а склонность к разрушению может повышаться до 21%.
Где проводят диагностику крови и какова стоимость каждого анализа?
В Москве можно сделать анализ крови в следующих местах:
- «СМ-Клиника»: общий анализ крови: 720 рублей;
- «Квадро-МЕД- Плюс»: общий анализ крови: 520 рублей; биохимия: 2000 рублей.
Важные замечания
Изменения уровня компонентов в крови не всегда говорит о том, что у человека анемия, например, изменение уровня трансферрина говорит о воспалительных процессах в организме или наличии других хронических заболеваний. Поэтому необходимо полностью обследовать пациентов.
Чтобы понять почему анализы крови отличаются от нормальных значений.
Вывод
Анализ крови является важным инструментов при обследовании больного и диагностировании анемии. С помощью ручной или автоматической обработки можно выявить отклонения от нормы во взятой порции крови или мазке. Это помогает своевременно назначить пациенту лечение, которое заключается в приёме железосодержащих препаратов, специальном питании, терапии заболеваний, которые провоцируют ЖДА.
Вопрос-ответ
Какие анализы крови необходимы для диагностики железодефицитной анемии?
Для диагностики железодефицитной анемии обычно проводят общий анализ крови, который показывает уровень гемоглобина и гематокрита. Также важны биохимические анализы, такие как определение уровня ферритина, сывороточного железа и общей железосвязывающей способности сыворотки (ОЖСС). Эти показатели помогают оценить запасы железа в организме и его транспорт.
Как часто нужно сдавать анализы крови при железодефицитной анемии?
Частота сдачи анализов крови зависит от степени анемии и назначения врача. Обычно анализы рекомендуются сдавать каждые 1-3 месяца для контроля уровня гемоглобина и состояния железа в организме. После достижения нормальных показателей, анализы можно сдавать реже, например, раз в полгода.
Что означают результаты анализов крови при железодефицитной анемии?
Результаты анализов могут показать низкий уровень гемоглобина и гематокрита, что указывает на анемию. Низкий уровень ферритина свидетельствует о дефиците запасов железа, а пониженную концентрацию сывороточного железа можно интерпретировать как недостаток этого элемента в организме. ОЖСС, как правило, будет повышена, что указывает на активное связывание железа, которое не хватает.
Советы
СОВЕТ №1
Перед сдачей анализа крови на уровень железа, старайтесь избегать физических нагрузок и стрессов. Это поможет получить более точные результаты, так как физическое состояние может повлиять на уровень железа в крови.
СОВЕТ №2
Обязательно сообщите врачу о всех принимаемых вами лекарствах и добавках, так как некоторые из них могут влиять на результаты анализов. Это поможет врачу правильно интерпретировать данные и назначить адекватное лечение.
СОВЕТ №3
Постарайтесь сдавать анализы натощак, так как это может улучшить точность результатов. Рекомендуется не есть за 8-12 часов до анализа, чтобы избежать влияния пищи на уровень железа и других показателей крови.
СОВЕТ №4
После получения результатов анализов, не стесняйтесь задавать вопросы своему врачу. Понимание своих показателей и их значения поможет вам лучше контролировать свое здоровье и принимать обоснованные решения о лечении.



